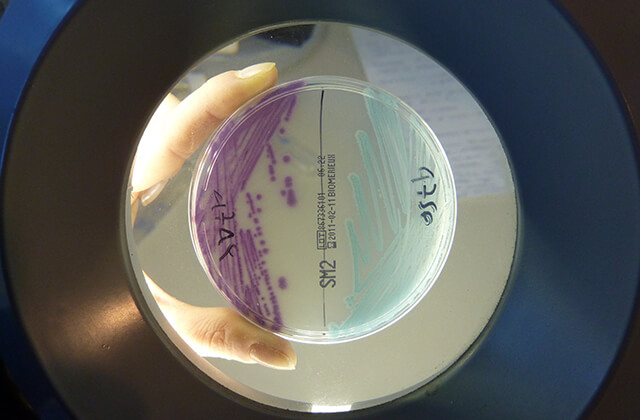

FARM group ha sottoscritto accordi con varie aziende farmaceutiche per le quali esegue e può eseguire:
- Analisi di metalli in tracce su intermedi, prodotti sperimentali, prodotti finiti con tecniche di ICP-OES, ICP-MS, XRF;
- Analisi di solventi residui tramite tecniche di HS statico o P&T (HS dinamico), GC-MS-IE e GC-MS-IC e GC-MS-MS;
- Spettri IR;
- Analisi elementare CHN;
- Diffrattometria RX;
- Termogravimetria DSC, TGA;
- Granulometria;
- Quantificazione di principi attivi, vitamine e metalli per integratori;
- Controlli microbiologici: Carica batterica, Carica micetica, Patogeni, Virus, Pirogeni.